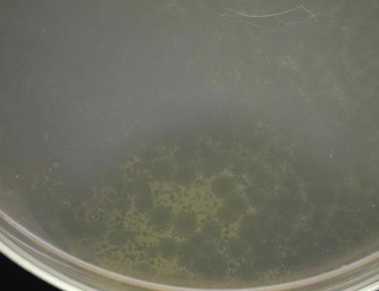

Вирусы бактерий. Бактериофаги. Классификация бактериофагов. Морфология бактериофагов. Типы бактериофагов.
Добавил пользователь Евгений Кузнецов Обновлено: 28.01.2026
Бактериофаги (фаги) - это вирусы, поражающие клетки бактерий. Они не имеют клеточной структуры, неспособны сами синтезировать нуклеиновые кислоты и белки, поэтому являются облигатными внутриклеточными паразитами.
Вирионы фагов состоят из головки, содержащей нуклеиновую кислоту вируса, и отростка.
Нуклеокапсид головки фага имеет кубический тип симметрии, а отросток - спиральный тип, т. е. бактериофаги имеют смешанный тип симметрии.
Фаги могут существовать в двух формах:
1) внутриклеточной (это профаг, чистая ДНК);
2) внеклеточной (это вирион).
Фаги, как и другие вирусы, обладают антигенными свойствами и содержат группоспецифические и типоспецифические антигены.
Различают два типа взаимодействия фага с клеткой:
1) литический (продуктивная вирусная инфекция). Это тип взаимодействия, при котором происходит репродукция вируса в бактериальной клетке. Она при этом погибает. Вначале происходит адсорбция фагов на клеточной стенке. Затем следует фаза проникновения. В месте адсорбции фага действует лизоцим, и за счет сократительных белков хвостовой части в клетку впрыскивается нуклеиновая кислота фага. Далее следует средний период, в течение которого подавляется синтез клеточных компонентов и осуществляется дисконъюнктивный способ репродукции фага. При этом в области нуклеоида синтезируется нуклеиновая кислота фага, а затем на рибосомах осуществляется синтез белка. Фаги, обладающие литическим типом взаимодействия, называют вирулентными.
В заключительный период в результате самосборки белки укладываются вокруг нуклеиновой кислоты и образуются новые частицы фагов. Они выходят из клетки, разрывая ее клеточную стенку, т. е. происходит лизис бактерии;
2) лизогенный. Это умеренные фаги. При проникновении нуклеиновой кислоты в клетку идет интеграция ее в геном клетки, наблюдается длительное сожительство фага с клеткой без ее гибели. При изменении внешних условий могут происходить выход фага из интегрированной формы и развитие продуктивной вирусной инфекции.
Клетка, содержащая профаг в геноме, называется лизогенной и отличается от исходной наличием дополнительной генетической информации за счет генов профага. Это явление лизогенной конверсии.
По признаку специфичности выделяют:
1) поливалентные фаги (лизируют культуры одного семейства или рода бактерий);
2) моновалентные (лизируют культуры только одного вида бактерий);
3) типовые (способны вызывать лизис только определенных типов (вариантов) бактериальной культуры внутри вида бактерий).
Фаги могут применяться в качестве диагностических препаратов для установления рода и вида бактерий, выделенных в ходе бактериологического исследования. Однако чаще их применяют для лечения и профилактики некоторых инфекционных заболеваний.
Данный текст является ознакомительным фрагментом.
Продолжение на ЛитРес
Бактериофаги в действии
Бактериофаги в действии Мы уже познакомились со строением вирусов. Узнали мы и об их сходстве с неживыми химическими соединениями. Теперь нам предстоит подробнее рассмотреть особенности, связывающие их с живыми организмами.Итак, мы уже знаем, что вирусы сходны с
ЛЕКЦИЯ № 4. Генетика микроорганизмов. Бактериофаги
ЛЕКЦИЯ № 4. Генетика микроорганизмов. Бактериофаги 1. Организация наследственного материала бактерий Наследственный аппарат бактерий представлен одной хромосомой, которая представляет собой молекулу ДНК, она спирализована и свернута в кольцо. Это кольцо в одной точке
3. Бактериофаги
3. Бактериофаги Бактериофаги (фаги) - это вирусы, поражающие клетки бактерий. Они не имеют клеточной структуры, неспособны сами синтезировать нуклеиновые кислоты и белки, поэтому являются облигатными внутриклеточными паразитами.Вирионы фагов состоят из головки,
Зараженный океан Морские вирусы-бактериофаги
Зараженный океан Морские вирусы-бактериофаги Некоторые великие открытия вначале напоминают чудовищные ошибки.В 1986 году выпускница Нью-Йоркского государственного университета Лита Проктор (Lita Proctor) решила узнать, как много вирусов содержится в морской воде. В то время
Бактериофаги, их строение, классификация, применение.
Бактериофаги - вирусы бактерий. История открытия бактериофага связана с именами Н.Ф. Гамалеи, наблюдавшего спонтанный лизис сибиреязвенных бактерий в 1898г. Английский бактериолог Ф. Туорт описал способность фильтрата стафилококков растворять свежую культуру этих же бактерий (1915г.). Французский ученый Ф.Д , Эррель подробно изучил взаимодействие фага и бактерий и сделал заключение, что открытый им литический агент является вирусом бактерий и назвал его «бактериофагом» - пожирателем бактерий.
Бактериофаги широко распространены: они выявлены у большинства бактерий, а также у других микроорганизмов, например, у грибов и поэтому их часто называют фагами. Наиболее детально изучена структура крупных фагов, к которым относятся фаги E. Coli (Т2, Т4, Т6). Они состоят из головки икосаэдрического типа, в которой заключена или ДНК, или РНК. Большинство фагов содержат двунитевую ДНК, замкнутую в кольцо. Хвостовой отросток имеет внутри полый цилиндрический стержень, сообщающийся с головкой, а снаружи - чехол, способный к сокращению наподобие мышцы. Чехол присоединен к воротничку, окружающему стержень около головки. Хвостовой отросток заканчивается шестиугольной базальной пластинкой с шипами от которых отходят нитевидные структуры - фибриллы.
По морфологии фаги подразделяются на 6 групп:
1) фаги с длинным отростком, чехол которого сокращается;
2) фаги с длинным отростком, чехол которого не сокращается;
3) фаги с короткими отростками;
4) фаги с аналогом отростка;
5)фаги без отростка;
6) нитевидные фаги.
Бактериофаги содержат группоспецифические и типоспецифические антигены, обладают иммуногенными свойствами, т.е. синтезируют специфические антитела в организме.
По специфичности взаимодействия фаги разделяют на :
- поливалентные (лизируют близкородственные бактерии, например сальмонеллы);
- моновалентные (лизируют бактерии одного вида);
- типоспецифические (лизируют только определенные фаговары возбудителя).
Взаимодействие фагов с бактериями может протекать:
1) по продуктивному типу - образуется фаговое потомство и бактерии лизируются;
2) по абортивному типу - фаговое потомство не образуется и бактерии сохраняют свою жизнедеятельность;
3) по интегративному типу - геном фага встраивается в хромосому бактерии и сосуществует с ней.
В зависимости от типа взаимодействия различают вирулентные и умеренные бактериофаги.
Вирулентные бактериофаги взаимодействуют с бактерией по продуктивному типу.
Взаимодействие фагов с клеткой (бактерией) строго специфично, т.е. бактериофаги способны инфицировать только определенные виды и фаготипы бактерий.
Основные этапы взаимодействия фагов и бактерий.
1. Адсорбция (взаимодействие специфических рецепторов).
2. Внедрение вирусной ДНК (инъекция фага) осуществляется за счет лизирования веществами типа лизоцима участка клеточной стенки, сокращения чехла, вталкивания стержня хвоста через цитоплазматическую мембрану в клетку, впрыскивание ДНК в цитоплазму.
3. Репродукция фага.
4. Выход дочерних популяций.
Умеренные бактериофаги в отличие от вирулентных взаимодействуют с чувствительными бактериями либо по продуктивному, либо по интегративному типам. При интегративном типе взаимодействия ДНК умеренного фага встраивается в хромосому бактерии, реплицируется синхронно с геном размножающейся бактерии, не вызывая ее лизиса. ДНК бактериофага, встроенная в хромосому бактерии, называется профагом, а культура бактерий - лизогенной. Такое сосуществование бактерии и умеренного бактериофага называется лизогенией.
Умеренные фаги имеют важное значение в обмене генетическим материалом между бактериями - в трансдукции (одна из форм генетического обмена). Например, способностью вырабатывать экзотоксин обладают только возбудитель дифтерии, в хромосому которого интегрирован умеренный профаг, несущий оперон tox, отвечающий за синтез дифтерийного экзотоксина. Умеренный фаг tox вызывает лизогенную конверсию нетоксигенной дифтерийной палочки в токсигенную.
Бактериофаги используют:
1) в лабораторной диагностике инфекций при внутривидовой идентификации бактерий, т.е. определения фаговара. Для этого применяют метод фаготипирования. На чашку с плотной питательной средой засевают «газоном» чистой культурой возбудителя и наносят капли различных диагностических типоспецифических фагов. Фаговар бактерии определяется тем типом фага, который вызвал ее лизис. Методику фаготипирования используют для выявления источника и путей распространения инфекции (эпидемиологическое маркирование). Например, при возникновении массовых заболеваний стафилококковой этиологии в родильных домах, детских и больничных учреждениях большое значение приобретает выявление источников инфекции и установление эпидемиологических связей. Решение этой задачи возможно только методом фаготипирования стафилококков, подтверждающим идентичность микроорганизмов, выделяемых у больных, носителей и объектов внешней среды. Таким образом, при проведении эпидемиологического обследования метод фаготипирования бактерий дает возможность: устанавливать или исключать предполагаемые источники инфекции; прослеживать эпидемические связи; отличать местные случаи от «привозных» и спородические заболевания от эпидемических.
2) фаги применяют также для лечения и профилактики ряда бактериальных инфекций. Производят брюшнотифозный, сальмонеллезный, дизентерийный, синегнойный, стафилококковый, стрептококковый фаги; комбинированные: колипротейный, пиобактериофаги. Бактериофаги назначают по показаниям перорально, парентерально или местно в виде жидких, таблетированных форм, свечей, аэрозолей.
3) бактериофаги широко применяют в генной инженерии в качестве векторов для получения рекомбинантных ДНК.
4) для оценки санитарного состояния окружающей среды и эпидемиологического анализа.
Бактериофаг
Бактериофаг - вирус, избирательно поражающий бактериальные клетки [1] .
Бактериофаги были открыты микробиологами Федериком Уильямом Туортом (Англия) и Феликсом д’Эреллем (Канада). Ф. Туорт в статье 1915 года описал инфекционную болезнь стафилококков, вызванную инфекционным агентом, способным проходит через бактериальные фильтры и быть перенесенным от одной колонии бактерий к другой. Д’Эрелль (независимо от Туорта) 3 сентября 1917 года сообщил об открытии таких же инфекционных агентов и ввел термин «бактериофаг» - пожирающий бактерии (отгреч. phagos - пожирающий) [3] [1] .
Содержание:
Состояние вопроса
В ходе длительных исследований достоверно установлено, что антибактериальный эффект препаратов бактериофагов основан на внедрении генома фага в клетку бактерии с последующим его размножением внутри ее и лизисом инфицированной клетки. После выхода во внешнюю среду фаги повторно инфицируют и лизируют другие клетки до полного уничтожения патогенных бактерий в очаге воспаления [3] [1] .
Бактериофаги отличаются высокой специфичностью действия в отношении штаммов-хозяев, отсутствием токсичности, не способностью вызывать аллергические реакции и дисбактериоз. Они могут применяться в качестве самостоятельного лекарственного средства, а так же совместно с антибиотиками и иммуноукрепляющими препаратами [3] [1] .
Несмотря на масштабы накопленного научного материала многие вопросы, касающиеся биологических свойств бактериофагов, требуют дополнительных исследований. В частности не выяснена функция многих продуктов, синтезируемых фагами, нет единой схемы таксономии и морфологической классификации, нет стандартных наборов бактериофагов многих возбудителей, схем и регламента их применения [3] [1] .
Развитие бактериофага в культуре бактерий рода Xanthomonas
Морфология и структура
Как и прочие вирусы, во внеклеточной форме бактериофаги являются метаболически инертными частицами. Бактериофаги различаются по химической структуре, типу нуклеиновой кислоты, строению фаговой частицы, морфологии негативных колоний, характеру взаимодействия с микробными клетками [1] .
Для обозначения бактериофагов используются буквы латинского и греческого алфавитов. В частности хорошо изучены фаги кишечной палочки: λ, ϕX174, fd, f2, R17, Т2 [1] .
Большинство из фагов относятся к сложным вирусам и состоят из хорошо сформированной икосаэдрической (кубической) головки и хвоста (отростка) различной степени выраженности, иногда имеющего дополнительные структуры. Все структуры отростка имеют белковую природу. Размер фага колеблется от 20 до 200 нм. Средний диаметр головки - от 60 до 100 нм, длина отростка - 100-200 нм. Длина хвоста, как правило, в 2-4 разабольше диаметра головки [2] [1] .
Головка состоит из генетического материала (двух цепочечной или одноцепочечной нуклеиновой кислоты (РНК или ДНК) с ферментом транскрипаза в неактивном состоянии) и капсида (белковой оболочки). Нуклеиновая кислота и капсид вместе образуют нуклеокапсид [1] .
Хвост представляет собой белковую полую трубку окруженную чехлом, содержащим сократительные белки. Чехол является продолжением белковой оболочки головки. В основании хвоста находится АТФ-аза, регенерирующая энергию для инъекции генетического материала (сокращения чехла отростка бактериофага). У некоторых вирусов чехол сокращается, обнажая часть стержня. На конце хвоста у многих фагов присутствует базальная пластинка с тонкими длинными нитями, способствующими прикреплению его к бактерии. Кроме того в области базальной пластинки присутствует фермент - бактериофаговый лизоцим, способный разрушать муреин клеточной стенки бактерии [2] [1] .
Морфологические типы
Описание структуры и морфологии бактериофагов приведенное выше соответствует наиболее изученным Т-фагам (типовым фагам). Они составляют группу коли-дизентерийных фагов, включающую 7 представителей: 4 нечетных Т1, ТЗ, Т5 и Т7 и 3 четных Т2, Т4, Т6 [1] .
Классические иди «хвостатые» фаги составляют основную массу бактериофагов, около 96%. Однако установлено, что тонкая структура фагов более разнообразна и сложна, чем структура фитопатогенных вирусов и зоопатогенных вирусов. В настоящее время исследовано большое количество фагов с морфологией отличной от представленной выше [1] .
По форме вирусных частиц фаги делятся на шесть основных морфологических типов:
Бактериофаги
Бактериофаги (от «бактерия» и греч. phagos — пожирающий)—вирусы бактерий, специфически проникающие в бактерии, паразитирующие в них вплоть до гибели (лизиса) бактериальной клетки.
Строение бактериофагов изучают с помощью электронной микроскопии образцов, контрастированных напылением металлов или фосфорно-вольфрамовой кислотой.
В зависимости от формы и структурной организации фаги подразделяют на несколько морфологических типов:
мелкие кубические (некоторые из них имеют аналоги отростков), без отростка, с коротким отростком, с длинным отростком;
фаги сперматозоидной формы, т. е. с кубической головкой и хвостовым отростком, имеющие сокращающийся или не сокращающийся чехол отростка.
Размеры фагов колеблются от 20 до 800 нм (нитевидный тип).
Наиболее изучены крупные бактериофаги, имеющие форму сперматозоида и сокращающийся чехол отростка, например, колифаги Т2, Т4, Т6. Они состоят из головки икосаэдрического типа размером 65—100 нм и хвостового отростка длиной более 100 нм (рис. 3.14).
Хвостовой отросток имеет внутри полый цилиндрический стержень, сообщающийся с головкой, а снаружи — чехол, способный к сокращению, наподобие мышцы. Чехол присоединен к воротничку, окружающему стержень около головки. На дистальном конце отростка имеется шестиугольная базальная ,пластинка с шипами, от которых отходят нитевидные структуры — фибриллы.
Бактериофаги содержат или ДНК, или РНК. Нуклеиновые кислоты фагов могут быть двунитевыми, однонитевыми, линейными, кольцевыми. Большинство фагов содержит двунитевую ДНК, замкнутую в кольцо.
У фагов, имеющих форму сперматозоида, одна молекула двунитевой суперспирализованной ДНК находится внутри головки и защищена капсидом. Капсид состоит из белковых молекул — идентичных полипептидных субъединиц, уложенных по икосаэдрическому (кубическому) типу симметрии. В состав головки также входит полипептид, состоящий из аспарагиновой, глутаминовой кислот и лизина. У некоторых фагов внутри головки находится внутренний гистоноподобный белок, обеспечивающий суперспирализацию ДНК. Сокращающийся чехол хвостового отростка образован также белковыми субъединицами, уложенными по спиральному типу симметрии, содержащими АТФ и ионы Са 2+ . У некоторых фагов (например, Т2) в дистальной части отростка содержится фермент лизоцим.
Антигенные свойства. Бактериофаги содержат группоспецифические и типоспецифические антигены, обладают иммуногенными свойствами, вызывая синтез специфических антител в организме. Антитела, взаимодействуя с бактериофагами, могут нейтрализовать их литическую активность против бактерий. По типоспецифическим антигенам фаги делят на серотипы.
Резистентность. По сравнению с вирусами человека бактериофаги более устойчивы к факторам окружающей среды. Инактивируются под действием температуры 65-70 °С, УФ-облучения в высоких дозах, ионизирующей радиации, формалина и кислот. Длительно сохраняются при низкой температуре и высушивании.
Взаимодействие фагов с бактериальной клеткой. Бактериофаги инфицируют строго определенные бактерии, взаимодействуя со специфическими рецепторами клетки.
По специфичности взаимодействия различают следующие бактериофаги:
поливалентные, взаимодействующие с родственными видами бактерий;
моновалентные, взаимодействующие с бактериями определенного вида;
типовые, взаимодействующие с отдельными типами (вариантами) бактерий данного вида.
Взаимодействие фагов с бактериями может протекать, как и у других вирусов, по:
При продуктивном типе взаимодействия образуется фаговое потомство, бактерии лизируются; при абортивном типе — фаговое потомство не образуется и бактерии сохраняют свою жизнедеятельность; при интегративном типе — геном фага встраивается в хромосому бактерии и сосуществует с ней.
В зависимости от типа взаимодействия различают вирулентные и умеренные бактериофаги.
Вирулентные бактериофаги взаимодействуют с бактерией по продуктивному типу. Проникнув в бактерию, они репродуцируются с образованием 200—300 новых фаговых частиц и вызывают лизис бактерий. Взаимодействие бактериофага с бактерией напоминает взаимодействие вирусов человека с клеткой хозяина. Специфическая адсорбция фагов на бактериальной клетке происходит при наличии комплементарных рецепторов липопротеиновой или липополисахаридной природы в ее клеточной стенке. На бактериях, лишенных клеточной стенки (протопласты, сферопласты), бактериофаги не адсорбируются. Некоторые фаги в качестве рецепторов используют половые пили бактерий.
Фаги, имеющие хвостовой отросток, прикрепляются к бактериальной клетке свободным концом отростка (фибриллами, базальной пластинкой). Проникновение фаговой нуклеиновой кислоты в бактерию наиболее изучено у бактериофагов, имеющих отросток с сокращающимся чехлом. В результате активации АТФ чехол хвостового отростка сокращается, и стержень с помощью лизоцима, растворяющего прилегающий фрагмент клеточной стенки, как бы просвер содержащаяся в его головке, проходит в форме нити через канал хвостового стержня и инъецируется в клетку, а капсид фага остается снаружи бактерии.
Некоторые мелкие кубические фаги, способные адсорбироваться на половых пилях, вводят свою нуклеиновую кислоту через канал этих пилей. ДНК нитевидных фагов проходит в бактерию вместе с одним из капсид-ных белков.
Инъецированная внутрь бактерии нуклеиновая кислота подавляет биосинтез компонентов клетки, заставляя ее синтезировать нуклеиновую кислоту и белки фага. Эти процессы схожи с репродукцией вирусов человека. После образования компонентов фага происходит самосборка частиц: сначала пустотелые капсиды головок заполняются нуклеиновой кислотой, затем сформированные головки соединяются с хвостовыми отростками. В результате изменения внутриклеточного осмотического давления и действия фагового лизоцима происходит разрушение оболочки, лизис бактерии и выход фагов из нее. Весь литический цикл от адсорбции бактериофага на бактерии до его выхода из нее занимает 20-40 мин.
Умеренные бактериофаги в отличие от вирулентных взаимодействуют с чувствительными бактериями либо по продуктивному, либо по интегративному типу. Продуктивный цикл умеренного фага идет в той же последовательности, что и у вирулентных фагов, и заканчивается лизисом клетки. При интегративном типе взаимодействия ДНК умеренного фага встраивается в хромосому бактерии, реплицируется синхронно с геномом размножающейся бактерии, не вызывая ее лизиса. ДНК бактериофага, встроенная в хромосому бактерии, называется профагом, а культура бактерий — лизогенной. Такое сосуществование бактерии и умеренного бактериофага называется лизогенией (от греч. lysis — разложение, genea — происхождение). Профаг, ставший частью хромосомы бактерии, при ее размножении передается по наследству потомкам.
Каким образом нуклеиновая кислота присоединяется к бактериальной хромосоме?После проникновения в бактерию ДНК умеренного фага приобретает форму кольца, а затем интегрирует по типу кроссинговера в строго определенную гомологичную область хромосомы клетки.
Итак, при лизогении образование фагового потомства не происходит. В основе «сдерживающего» механизма репродукции фагов лежит образование в бактерии специфического репрессора — низкомолекулярного белка, подавляющего транскрипцию фаговых генов. Биосинтез репрессора детерминируется генами профага. Наличием репрессора можно объяснить способность лизогенных бактерий приобретать иммунитет (невосприимчивость) к последующему заражению гомологичным или близкородственными фагами. Под иммунитетом в данном случае понимается такое состояние бактерии, при котором исключается процесс вегетативного размножения вышеуказанных фагов и лизис клетки. Однако термин «лизогения» отражает потенциальную возможность лизиса бактерии, содержащей профаг. Действительно, профаги некоторой части лизогенной культуры бактерий могут спонтанно (самопроизвольно) или направленно под действием ряда физических или химических факторов дерепрессироваться, исключаться из хромосомы, переходить в вегетативное состояние. Этот процесс заканчивается продукцией фагов и лизисом бактерий. Частота спонтанного лизиса бактерий в лизогенных культурах невелика (10 2 , 10~ 6 ), т. е. не захватывает все клетки, обладающие иммунитетом. Частоту лизиса бактерий можно значительно увеличить, воздействуя на лизогенную культуру индуцирующими агентами (УФ-лучи, ионизирующее излучение, перекисные соединения, митомицин С и др.). Сам же феномен воздействия, приводящий к инактивации репрессора, называется индукцией профага. Явление индукции используют в генной инженерии. Однако спонтанный лизис лизогенных культур может нанести вред микробиологическому производству. Так, если микроорганизмы — продуценты биологически активных веществ оказываются лизогенными, существует опасность перехода фага в вегетативное состояние, что приведет к лизису производственного штамма этого микроба.
Геном профага может придавать бактерии новые, ранее отсутствовавшие у нее свойства. Этот феномен изменения свойств микроорганизмов под влиянием профага получил название фаговой конверсии (от лат. conver-sio— превращение). Конвертироваться могут морфологические, культуральные, биохимические, антигенные и другие свойства бактерий. Например, наличие профага в дифтерийной палочке обусловливает ее способность продуцировать дифтерийный экзотоксин.
Умеренные фаги могут быть дефектными, т. е. неспособными образовывать зрелые фаговые частицы ни в естественных условиях, ни при индукции. Геном некоторых умеренных фагов (Р1) может находиться в цитоплазме бактериальной клетки в так называемой плаз-мидной форме, не включаясь в ее хромосому. Такого рода умеренные фаги используют в качестве векторов в генной инженерии.
Практическое применение фагов. Бактериофаги используют в лабораторной диагностике инфекций при внутривидовой идентификации бактерий, т. е. определении фаговара (фаготипа). Для этого применяют метод фаготипирования, основанный на строгой специфичности действия фагов: на чашку с плотной питательной средой, засеянной «газоном» чистой культурой возбудителя, наносят капли различных диагностических типоспецифических фагов. Фаговар бактерии определяется тем типом фага, который вызвал ее лизис (образование стерильного пятна, «бляшки», или «негативной колонии», фага). Методику фаготипирования используют для выявления источника и путей распространения инфекции (эпидемиологическое маркирование). Выделение бактерий одного фаговара от разных больных указывает на общий источник их заражения.
По содержанию бактериофагов в объектах окружающей среды (например, в воде) можно судить о присутствии в них соответствующих патогенных бактерий. Подобные исследования проводят при эпидемиологическом анализе вспышек инфекционных болезней.
Фаги применяют также для лечения и профилактики ряда бактериальных инфекций. Производят брюшнотифозный, сальмонел-лезный, дизентерийный, синегнойный, стафилококковый, стрептококковый фаги и комбинированные препараты (колипротейный, пиобактериофаги и др). Бактериофаги назначают по показаниям перорально, парентерально или местно в виде жидких, таблетированных форм, свечей или аэрозолей.
Бактериофаги широко применяют в генной инженерии в качестве векторов для получения рекомбинантных ДНК.
Качественный метод определения фагов E.coli. Чашку Петри с питательным агаром засевают суточной бульонной культурой кишечной палочки газоном и подсушивают при 37 "С в течение 10—15 мин. Затем на поверхность газона наносят каплю фага и наклоняют так, чтобы капля стекла к противоположному краю. После суточной инкубации в термостате просматривают чашку, отмечая наличие зоны лизиса по месту стекания капли фага.
Количественный метод — определение титра фага по методу Грациа. Для постановки опыта предварительно: а) разливают питательный агар в чашки Петри, подсушивают в термостате; б) приготовленный полужидкий (0,7 %) питательный агар, разлитый по 3—4 мл в пробирки, растапливают в водяной бане. Делают 10-кратные разведения исследуемого фага (10~ 2 —10~ 7 в зависимости от предполагаемого титра) в изотоническом растворе хлорида натрия. Затем 0,5 мл из последнего разведения фага (10~ 7 ) смешивают с таким же объемом суточной бульонной культуры чувствительных к фагу бактерий и выливают в пробирку с полужидким агаром, охлажденным до 45 "С. Смесь быстро выливают на поверхность агара в чашке Петри, где она застывает в виде тонкого слоя. Так же готовят смесь из следующего разведения фага (10~ 6 ) с бактериями и полужидким агаром и выливают на поверхность агара в другой чашке, затем — из разведения 10~ 5 . После застывания второго слоя агара чашки инкубируют при 37 *С, затем подсчитывают число негативных колоний фага. Число этих колоний соответствует количеству фаговых частиц в засеянной смеси. Исходя из него, можно вычислить количество пятнообразующих единиц в 1 мл исходной суспензии фага. Эта величина, характеризующая концентрацию фага, называется его титром (табл. 5.3.1).
Определение спектра литического действия фага. Чашку с питательным агаром делят на квадраты по числу испытуемых бактериальных культур. На каждый квадрат петлей наносят каплю соответствующей бульонной культуры и распределяют ее по агару в пределах данного квадрата. Затем на каждый засеянный квадрат петлей или пастеровской пипеткой наносят по одной капле испытуемого фага. После суточной инкубации в термостате просматривают чашку, отмечая те квадраты, где имеется сплошной лизис бактерий или так называемые стерильные пятна набактериальном газоне. Количество различных бактериальных культур, которые лизируются испытуемым фагом, определяет широту спектра его литического действия.
Фаготипирование бактерий. Испытуемую суточную бульонную культуру бактерий засевают на поверхность питательного агара в чашке Петри, слегка подсушивают в термостате, затем делят на квадраты, на которые пастеровской пипеткой наносят по одной капле различных типоспецифических фагов. После суточной инкубации отмечают на чашке те квадраты, в которых имеется сплошной лизис бактерий. Фаготип бактериальной культуры определяется тем типом фага, который вызывает ее лизис.
Определение лизогении. Исследуемую суточную бульонную культуру центрифугируют для отделения фага от бактерий. В том случае, если бактерии спонтанно продуцируют фаг, последний будет содержаться в надосадочной жидкости. Для выявления фага надосадочную жидкость засевают на газон индикаторной (чувствительной) бактериальной культуры, на котором через
1 сут инкубации при 37 "С образуются очаги лизиса — "стерильные" пятна. При отрицательном результате опыта исследуемую бактериальную культуру предварительно подвергают УФ-облучению с целью индукции содержащегося в ней профага. Затем поступают так же, как и в предыдущем опыте.
32. Бактериофаги. Морфология и химический состав.
Бактериофа́ги или фа́ги (от др.-греч. φᾰγω — «пожираю») — вирусы, избирательно поражающие бактериальные клетки. Бактериофаг присутствует там, где находятся чувствительные к нему бактерии. Бактериофаги - неклеточные формы жизни
содержат одну нуклеиновую кислоту - ДНК или РНК
у них отсутствуют белоксинтезирующие системы и самостоятельный метаболизм
облигатные внутриклеточные паразиты на генетическом уровне Химический состав бактериофагов Белок - 50-60% ДНК 40 - 50%
Имеются также РНК - содержащие бактериофаги, «лизирующие только мужские клетки бактерий»
Углеводы и липиды- небольшие количества На конце стержня обнаружены лизоцим и гиалуронидаза.
По признаку специфичности выделяют:
1. поливалентные фаги (лизируют культуры одного семейства или рода бактерий);
2. моновалентные (лизируют культуры только одного вида бактерий);
3. Типовые (способны вызывать лизис только определенных типов (вариантов) бактериальной культуры внутри вида бактерий)
Морфология бактериофагов.
Бактериофаги различаются по химической структуре, типу нуклеиновой кислоты, морфологии и характеру взаимодействия с бактериями. По размеру бактериальные вирусы в сотни и тысячи раз меньше микробных клеток.
Применение современных электронных микроскопов, а также усовершенствование методов приготовления препаратов для электронной микроскопии позволили более детально изучить тонкую структуру фагов. Оказалось, что она весьма разнообразна и у многих фагов более сложна, чем структура вирусов растений и ряда вирусов человека и животных.

Рис.1 Морфологические типы фагов.
I.По форме частиц фаги делятся на шесть основных морфологических типов:
1) Палочковидные или нитевидные фаги;
Фаги первого морфологического типа - палочковидные или нитевидные - выявлены у кишечной, синегнойной, чудесной палочек и других бактерий. Средние размеры их: длина - от 7000 до 8500 А, ширина - от 50 до 80 А . Эти фаги отличаются от всех остальных не только большой специфичностью, но и рядом других важных свойств.
2) Фаги, состоящие из одной головки, без отростка;
Фаги второго морфологического типа. Частица их состоит из одной головки гексагональной (шестигранной) формы на плоскости. Частицы очень мелкие, средний размер их 230-300 А в диаметре .
3) Фаги, состоящие из головки, на которой имеется несколько небольших выступов;
У фагов третьего морфологического типа форма и размеры головки такие же, как у фагов второго типа, но у их головок имеются обычно несколько очень коротких выступов. Возможно, эти выступы являются аналогами отростков.
Фаги второго и третьего морфологических типов отличаются постоянством формы и размеров, независимо от того, против каких микроорганизмов они активны. Эти фаги относятся к мелким формам.
4) Фаги, состоящие из головки и весьма короткого отростка;
Фаги четвертого морфологического типа. Частица состоит из головки, размеры которой варьируют от 400 до 640 А в диаметре, и очень короткого отростка. Длина и ширина отростка от 70 до 200 А.
Читайте также:
